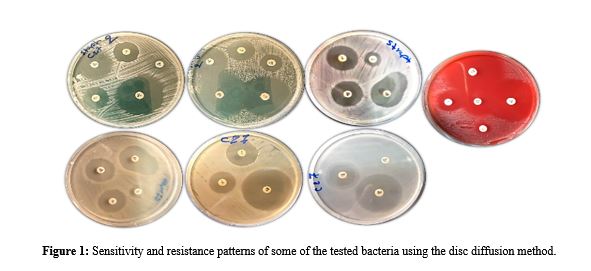

COMPARATIVE ANTIMICROBIAL EFFICACY OF LAVENDER AND MINT ESSENTIAL OILS: A PROMISING ALTERNATIVE FOR VETERINARY APPLICATIONS
Abstract
With the increasing prevalence of antimicrobial resistance (AMR) in veterinary pathogens, there is a growing need to explore alternative therapeutic options. This study presents a direct comparative analysis of the antimicrobial efficacy of mint and lavender essential oils (EOs) against key veterinary pathogens, including Escherichia coli, Pasteurella multocida, Proteus mirabilis, Klebsiella pneumoniae, Corynebacterium pseudotuberculosis, Streptococcus agalactiae, and methicillin-resistant Staphylococcus aureus (MRSA). Antimicrobial potency was investigated through the determination of minimum inhibitory concentration (MIC) and minimum bactericidal concentration (MBC), along with conducting time-kill assays and antibiotic interaction studies using disc diffusion and broth dilution methods. While both essential oils have potential as alternative antimicrobial agents, lavender EO stands out, especially against drug-resistant bacteria like MRSA. Lavender EO was more bactericidal, killing most isolates within four hours, whereas mint EO needed a full 24 hours for its full efficacy. MICs ranged between 12 and 40 µL/mL, with slightly lower MICs with lavender against K. pneumoniae. Noticeably, Lavender EO demonstrated a strong synergistic effect with antibiotics, particularly enhancing the efficacy of penicillin and tetracycline against MRSA. In contrast, mint EO exhibited only limited synergy and, at times, an antagonistic interaction. These findings highlight the superior antimicrobial potential of lavender EO over mint EO, underscoring its therapeutic value in veterinary medicine
Full text article
References
Martini, K.M. et al. (2024). Maximum likelihood estimators for colony-forming units’, Microbiology Spectrum, 12(9), pp. 1–17. DOI: https://doi.org/10.1128/spectrum.03946-23.
Aelenei, P., Miron, A., Trifan, A., Bujor, A., Gille, E., and Aprotosoaie, A. (2016). Essential Oils and Their Components as Modulators of Antibiotic Activity against Gram-Negative Bacteria. Medicines, 3(3), 19. DOI: https://doi.org/10.3390/medicines3030019
Ahmed, B., and Abdullah, M. (2022). Isolation and molecular diagnosis of the main bacterial species causing Pneumonia in small ruminants in the Duhok Abattoir-Kurdistan region of Iraq. Microbial Biosystems, 7(2). DOI: https://doi.org/10.21608/mb.2023.193960.1069
Anwer, S. S., Ali, A. K., and Şule İnci. (2024). The Investigation of Elements Affecting Certain Microalg’S Development and Possible Antibacterial Properties. Science Journal of University of Zakho, 12(3), 299–307. DOI: https://doi.org/10.25271/sjuoz.2024.12.3.1286
Asad, F., Nasir, S., Fatima, I., Selamoglu, Z., Nadeem, A., Jamal, R., and Fatima, M. (2025). Assessment of bactericidal role of epidermal mucus of major carps against pathogenic microbial strains. Science Journal of University of Zakho, 13(1), 71–76. DOI: https://doi.org/10.25271/sjuoz.2025.13.1.1410
Başaran, S. N., and Öksüz, L. (2023). The role of efflux pumps ın antıbıotıc resıstance of gram negatıve rods. Archives of Microbiology, 15;205(5):192. DOI: https://doi.org/10.1007/s00203-023-03539-3
Batiha, G. E. S., Teibo, J. O., Wasef, L., Shaheen, H. M., Akomolafe, A. P., Teibo, T. K. A., Al-kuraishy, H. M., Al-Garbeeb, A. I., Alexiou, A., and Papadakis, M. (2023). A review of the bioactive components and pharmacological properties of Lavandula species. Naunyn-Schmiedeberg’s Archives of Pharmacology, 396(5):877-900. DOI: https://doi.org/10.1007/s00210-023-02392-x
Clinical, and Institute, L. S. (2022). Performance standards for antimicrobial disk and dilution susceptibility tests for bacteria isolated from animals. VET01S-Ed5. CLSI Supplement VET08.
Di Matteo, A., Lavorgna, M., Russo, C., Orlo, E., and Isidori, M. (2024). Natural plant-derived terpenes: antioxidant activity and antibacterial properties against foodborne pathogens, food spoilage and lactic acid bacteria. Applied Food Research, 4(2), 100528. DOI: https://doi.org/10.1016/j.afres.2024.100528
Ellouze, I., Ben Akacha, B., Mekinić, I. G., Ben Saad, R., Kačániová, M., Kluz, M. I., Mnif, W., Garzoli, S., and Ben Hsouna, A. (2024). Enhancing Antibacterial Efficacy: Synergistic Effects of Citrus aurantium Essential Oil Mixtures against Escherichia coli for Food Preservation. Foods, 13(19). DOI: https://doi.org/10.3390/foods13193093
Eslami, M., Safaripour, A., Banihashemian, S. Z., and Niaragh, S. N. (2025). Innovative Antibiotic Therapies for Carbapenem-Resistant Gram-Negative Bacterial Infections : Clinical Efficacy , Safety , and Comparative Studies. Microorganisms, 13(2), 295; DOI: https://doi.org/10.3390/microorganisms13020295
Gasparrini, A. J., Markley, J. L., Kumar, H., Wang, B., Fang, L., Irum, S., Symister, C. T., Wallace, M., Burnham, C. A. D., Andleeb, S., Tolia, N. H., Wencewicz, T. A., and Dantas, G. (2020). Tetracycline-inactivating enzymes from environmental, human commensal, and pathogenic bacteria cause broad-spectrum tetracycline resistance. Communications Biology, 3, 241 (2020). DOI: https://doi.org/10.1038/s42003-020-0966-5
Guillín, Y., Cáceres, M., Torres, R., Stashenko, E., and Ortiz, C. (2021). Effect of essential oils on the inhibition of biofilm and quorum sensing in salmonella enteritidis 13076 and salmonella typhimurium 14028. Antibiotics, 1;10(10):1191. DOI: https://doi.org/10.3390/antibiotics10101191
Hajiagha, M. N., and Kafil, H. S. (2023). Efflux pumps and microbial biofilm formation. Infection, Genetics and Evolution, 112, 105459 DOI: https://doi.org/10.1016/j.meegid.2023.105459
Halat, D. H., Krayem, M., Khaled, S., and Younes, S. (2022). A Focused Insight into Thyme: Biological, Chemical, and Therapeutic Properties of an Indigenous Mediterranean Herb. Nutrients. 18;14(10):2104. DOI: https://doi.org/10.3390/nu14102104
Hami, I. A., and Ibrahim, K. S. (2023). Incidence of Methicillin-Resistant Staphylococcus Aureus (MRSA) Recovered from Patients with Urinary Tract Infections in Zakho City/ Kurdistan-Iraq. Science Journal of University of Zakho. 11(1), 91– 97. DOI: https://doi.org/10.25271/sjuoz.2023.11.1.1041
Hudz, N., Kobylinska, L., Pokajewicz, K., Horčinová Sedláčková, V., Fedin, R., Voloshyn, M., Myskiv, I., Brindza, J., Wieczorek, P. P., and Lipok, J. (2023). Mentha piperita: Essential Oil and Extracts, Their Biological Activities, and Perspectives on the Development of New Medicinal and Cosmetic Products. Molecules. 6;28(21):7444. DOI: https://doi.org/10.3390/molecules28217444
Imran, M., Aslam, M., Alsagaby, S. A., Saeed, F., Ahmad, I., Afzaal, M., Arshad, M. U., Abdelgawad, M. A., El-Ghorab, A. H., Khames, A., Shariati, M. A., Ahmad, A., Hussain, M., Imran, A., and Islam, S. (2022). Therapeutic application of carvacrol: A comprehensive review. Food Science and Nutrition, 3;10(11):3544–3561.DOI: https://doi.org/10.1002/fsn3.2994
Issa, F. A. (2024). Antibiotic resistance patterns of common uropathogens isolated from females at Zakho city , Kurdistan region , Iraq. Science Journal of University of Zakho.12(4), 490–496. https://doi.org/10.25271/sjuoz.2024.12.4.1395.
Issa, N. A. (2024). Evaluation the Antimicrobial Activity of Essential Oils against Veterinary Pathogens, Multidrug-resistant Bacteria and Dermatophytes. Pakistan Veterinary Journal, 44(2), 260–265. https://doi.org/10.29261/pakvetj/2024.165
Kajjari, S., Joshi, R. S., Hugar, S. M., Gokhale, N., Meharwade, P., and Uppin, C. (2022). The Effects of Lavender Essential Oil and its Clinical Implications in Dentistry: A Review. International Journal of Clinical Pediatric Dentistry, 15(3):385–388.DOI: https://doi.org/10.5005/jp-journals-10005-2378
Khanamir, R. A., Issa, N. A., and Abdulrahman, R. F. (2023). First study on molecular epidemiology of caseous lymphadenitis in slaughtered sheep and goats in Duhok Province, Iraq. Open Veterinary Journal, 13(5): 588-598. DOI: https://doi.org/10.5455/OVJ.2023.v13.i5.11
Khleifat, K. M., Matar, S. A., Jaafreh, M., Qaralleh, H., Al-Limoun, M. O., and Alsharafa, K. Y. (2019). Essential oil of centaurea damascena aerial parts, antibacterial and synergistic effect. Journal of Essential Oil-Bearing Plants, 22(2): 356-367.DOI: https://doi.org/10.1080/0972060X.2019.1626292
Moghrovyan, A., and Sahakyan, N. (2024). Antimicrobial activity and mechanisms of action of Origanum vulgare L. essential oil: effects on membrane-associated properties. AIMS Biophysics, 11(4), 508–526. DOI: https://doi.org/10.3934/BIOPHY.2024027
Mohamed, A. A., and Alotaibi, B. M. (2023). Essential oils of some medicinal plants and their biological activities: a mini review. Journal of Umm Al-Qura University for Applied Sciences, 9, 40–49. DOI: https://doi.org/10.1007/s43994-022-00018-1
Pedroso, M. B., Scariot, F. J., Rocha, R. K. M., Echeverrigaray, S., and Delamare, A. P. L. (2024). Antifungal activity and mechanism of action of monoterpenes against Botrytis cinerea. Ciencia e Agrotecnologia, 48, 1–8. DOI: https://doi.org/10.1590/1413-7054202448018823
Posgay, M., Greff, B., Kapcsándi, V., and Lakatos, E. (2022). Effect of Thymus vulgaris L. essential oil and thymol on the microbiological properties of meat and meat products: A review. Heliyon, 8, (10), e10812. DOI: https://doi.org/10.1016/j.heliyon.2022.e10812
Raikwar, G., Kumar, D., Mohan, S., and Dahiya, P. (2024). Synergistic potential of essential oils with antibiotics for antimicrobial resistance with emphasis on mechanism of action: A review. Biocatalysis and Agricultural Biotechnology, 61, 103384. DOI: https://doi.org/10.1016/j.bcab.2024.103384
Rasol, V. A., and Abdulrahman, R. F. (2023). Detection and Molecular Characterization of Staphylococcus aureus and Methicillin-Resistant Staphylococcus aureus (MRSA) Nasal Carriage Isolates from Healthy Domestic Animal in Duhok Province. Egyptian Journal of Veterinary Sciences, 54 (2): 263-273. DOI: https://doi.org/10.21608/ejvs.2022.168434.1404
Salam, M. A., Al-Amin, M. Y., Salam, M. T., Pawar, J. S., Akhter, N., Rabaan, A. A., and Alqumber, M. A. A. (2023). Antimicrobial Resistance: A Growing Serious Threat for Global Public Health. Healthcare (Switzerland), 11(13), 1946. DOI: https://doi.org/10.3390/healthcare11131946
Semerdjieva, I., Cantrell, C. L., Zheljazkov, V. D., Radoukova, T., Koleva-Valkova, L. H., Astatkie, T., Kačániová, M., and Borisova, D. (2024). Chemical profile, antioxidant and antimicrobial activity of Pinus heldreichii Christ. Distributed in Bulgaria. Heliyon, 10, (1), e22967. DOI: https://doi.org/10.1016/j.heliyon.2023.e22967
Shariati, A., Arshadi, M., Khosrojerdi, M. A., Abedinzadeh, M., Ganjalishahi, M., Maleki, A., Heidary, M., and Khoshnood, S. (2022). The resistance mechanisms of bacteria against ciprofloxacin and new approaches for enhancing the efficacy of this antibiotic. Frontiers in Public Health, 21;10:1025633. DOI: https://doi.org/10.3389/fpubh.2022.1025633
Sriti, J., Haj Salem, M., Aidi Wannes, W., Bachrouch, O., Mejri, H., Belloumi, S., Fares, N., Jallouli, S., Haoual-Hamdi, S., Mediouni-Ben Jemâa, J., and Limam, F. (2024). Antioxidant, antibacterial and insecticidal activities of cypress (Cupressus sempervirens L.) essential oil. International Journal of Environmental Health Research, 34(2):1168-1179. DOI: https://doi.org/10.1080/09603123.2023.2207475
Sy, C. L., Huang, T. S., Chen, C. S., Chen, Y. S., Tsai, H. C., Wann, S. R., Wu, K. S., Chen, J. K., Lee, S. S. J., and Liu, Y. C. (2016). Synergy of β-Lactams with Vancomycin against Methicillin-Resistant Staphylococcus aureus: Correlation of Disk Diffusion and Checkerboard Methods. Journal of Clinical Microbiology, 25;54(3):565–568. DOI: https://doi.org/10.1128/JCM.01779-15
Tambe, P., Shaikh, S., Parkar, S., Tambe, S., Oberoi, J. K., Ahmed, K., Shaikh, S., and Shah, A. (2023). Original article Synergistic and Antagonistic effects of essential oil extracts against Escherichia coli , Pseudomonas spp ., Staphylococcus spp . and Candida sp. Bulletin of Environment, Pharmacology and Life Sciences, (1): 197-201.
Trinchera, M., Midiri, A., Mancuso, G., Lagrotteria, M. A., De Ani, C. A., and Biondo, C. (2025). A Four-Year Study of Antibiotic Resistance, Prevalence and Biofilm-Forming Ability of Uropathogens Isolated from Community- and Hospital-Acquired Urinary Tract Infections in Southern Italy. Pathogens, 14(1), 59. DOI: https://doi.org/10.3390/pathogens14010059
Wasfi, R., Hamed, S. M., Amer, M. A., and Fahmy, L. I. (2020). Proteus mirabilis Biofilm: Development and Therapeutic Strategies. In Frontiers in Cellular and Infection Microbiology, (10).DOI: https://doi.org/10.3389/fcimb.2020.00414
Yap, P. S. X., Yusoff, K., Lim, S. H. E., Chong, C. M., and Lai, K. S. (2021). Membrane disruption properties of essential oils-a double-edged sword? Processes, 9(4), 595. DOI https://doi.org/10.3390/pr9040595
Zhang, Y., Zhang, N., Wang, M., Luo, M., Peng, Y., Li, Z., Xu, J., Ou, M., Kan, B., Li, X., and Lu, X. (2023). The prevalence and distribution of aminoglycoside resistance genes. Biosafety and Health, 5(1);14-20. DOI: https://doi.org/10.1016/j.bsheal.2023.01.001
Authors
Copyright (c) 2025 Nawzat Aboziad Issa, Renas Ihsan Abdulkarim

This work is licensed under a Creative Commons Attribution 4.0 International License.
Authors who publish with this journal agree to the following terms:
- Authors retain copyright and grant the journal right of first publication with the work simultaneously licensed under a Creative Commons Attribution License [CC BY-NC-SA 4.0] that allows others to share the work with an acknowledgment of the work's authorship and initial publication in this journal.
- Authors are able to enter into separate, additional contractual arrangements for the non-exclusive distribution of the journal's published version of the work, with an acknowledgment of its initial publication in this journal.
- Authors are permitted and encouraged to post their work online.